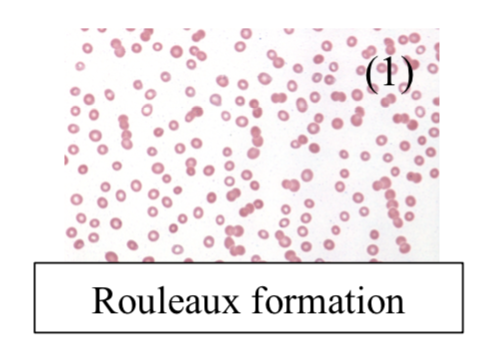

Back to: Haematology
Plasma Cell Disorders
Abnormal plasma cell proliferation gives excessive secretion of immunoglobin giving organ dysfunction.
– The urine of these patients contains Bence Jones proteins (free Ig chains) which are filtered by the kidney.
Multiple Myeloma
This is due to proliferation of plasma cells in the bone marrow, usually seen around age of 70.
– Plasma cells crowd out hematopoiesis, activate osteoclasts and produce excessive levels of antibodies.
Symptoms
– These primarily are caused by increased osteoclast activity and Ig production
i) Osteoclast activity:
– Bone pain –> osteoclasts cause bone resorption with punched out lesions
– Hypercalcemia –> increase bone resorption elevates serum Ca2+
ii) Ig Production:
– Bone marrow failure –> anaemia, bleeding and infection (common cause of death)
– Renal damage –> Ig light chains deposit in kidney tubules leading to kidney failure
– Primary AL amyloidosis –> gives elevated serum protein
Tests:
– Blood –> FBC shows anaemia and Raised Urea/creatinine
– Blood film –> shows rouleaux (linked RBCs)
– Bone marrow biopsy –> raised plasma cells
– Whole body MRI –> shows bone lesions
– Serum or urine electrophoresis shows IgA/IgG
– X-ray shows is “rain drop skull” appearance

Diagnosis:
This is confirmed by 3 factors:
– Plasma cells in Marrow > 10%
– Protein in urine/serum by electrophoresis
– End-organ damage
Management:
It is a chronic relapse-remitting malignancy, so monitor and manage complications
– If aggressive disease, then use chemotherapy or bone marrow transplant
– For relapse, one option is Bortezomib (proteasome inhibitor which induces apoptosis)
– If not suitable for bone marrow transplant then less intense chemotherapy is used.
Monoclonal Gammopathy of Undetermined significance (MGUS)
This is increased serum clonal antibodies, but all the other features of multiple myeloma are absent
– Common in elderly and is benign but it can lead to multiple myeloma
– No bone lesions, normal immune function, and lower paraproteinemia
Waldrenstrom Macroglobinaemia
This is a B-cell lymphoma with monoclonal IgM production which is seen in elderly males
– The B cell proliferation leads to lymphoma symptoms plus hyperviscosity due to IgM production
Symptoms:
– B Cell symptoms (weight loss, lethargy, lymphadenopathy, hepatosplenomegaly)
– IgM increased viscosity –> Visual and neurological deficit
– Raynaud’s phenomenon
Management:
Chemotherapy for lymphoma + plasmapheresis for hyperviscosity (removes IgM from serum)
Amyloidosis
This is a condition which is due to the deposition of a protein called amyloid. This is an insoluble fibrillar protein which is resistant to degradation.
– In addition to the fibrillar component, it also contains a non-fibrillar part called amyloid P-component
– The condition is divided according to whether it is systemic or localised and further characterized by the precursor protein it is made from:
– AL in myeloma – A = Amyloid, L = immunoglobulin Light chain)
– Median survival is 1-2 years, and is worse if they have myeloma as well
Diagnosis:
This is made with biopsy of the affected tissue, usually a rectal biopsy is taken
– Congo Red staining used –> shows apple-green birefringence
– Serum amyloid precursor (SAP) scan –> shows raised amyloid precursor coating organs
The symptoms and management are different depending on the type of amyloidosis present.
AL amyloid (Primary Amyloidosis)
This is when proliferation of plasma cells gives raised fibrillar immunoglobin light chains which get deposited in organs causing organ failure.
Associations:
Multiple myeloma, Lymphoma
Symptoms:
– Kidney –> proteinuria and nephrotic syndrome
– Heart –> restrictive cardiomyopathy, arrhythmias
– Nerves -> peripheral and autonomic neuropathy
– Gut –> macroglossia, weight loss, obstruction
– Periorbital purpura is characteristic (as shown here)

Management:
– Melphalan + stem cell transplantation is ideal
– If not tolerated, then melphalan + prednisolone
AA Amyloid (Secondary amyloidosis)
This is when amyloid is derived from serum amyloid A, an acute phase protein, and so it is seen in chronic inflammatory states
Associations:
Chronic inflammation (RA, IBD) + chronic infection (TB)
Symptoms:
Same as primary but usually no macroglossia or cardiac involvement
Management:
Treat underlying condition
Familial Amyloidosis
This is due to an autosomal dominant mutation in liver protein which gives raised amyloid
Symptoms:
Sensory or autonomic neuropathy with possible cardio/renal involvement
Management:
Liver transplant
Sources
Image 1: Gabriel Caponetti, CC BY-SA 3.0 <https://creativecommons.org/licenses/by-sa/3.0>, via Wikimedia Commons
Image 2: Nephron, CC BY-SA 3.0 <https://creativecommons.org/licenses/by-sa/3.0>, via Wikimedia Commons
Image 3: Kyle RA, Bayrd ED: Amyloidosis: Review of 236 Cases. Medicine 1975 Jul; 54(4):271-99. PubMed


